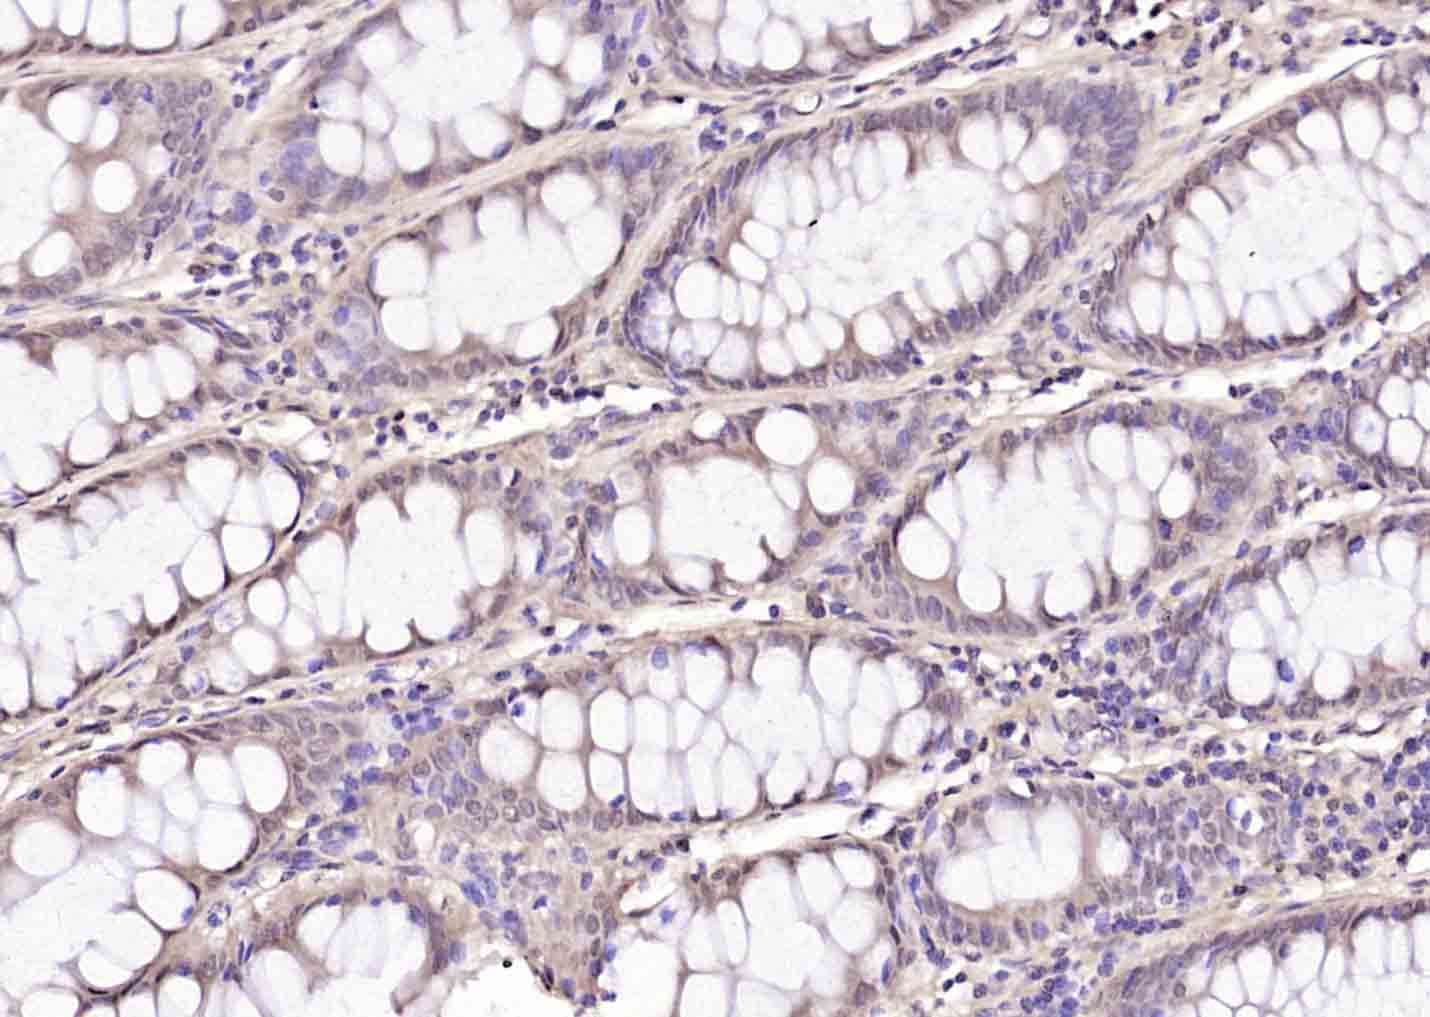
产品细节图片2

相关产品推荐更多 >

KLF6 Rabbit pAb(bs-1395R)-50ul/100ul/200ul
¥1180
phospho-ATF2 (Thr69 / Thr51) Rabbit pAb(bs-12538R)-50ul/100ul/200ul
¥1180
IL-1 beta Recombinant Rabbit mAb(bsm-52727R)-50ul/100ul/25ul
¥800
phospho-STAT5b (Ser731) Rabbit pAb, PE conjugated(bs-5703R-PE)-100ul
¥2980
C1orf192 Rabbit pAb(bs-15051R)-50ul/100ul/200ul
¥1180
万千商家帮你免费找货
0 人在求购买到急需产品
- 详细信息
- 文献和实验
- 技术资料
- 应用范围:
产品信息以Bioss网站为准
- 规格:
50ul/100ul/200ul
| 规格: | 50ul | 产品价格: | ¥1180.0 |
|---|---|---|---|
| 规格: | 100ul | 产品价格: | ¥1980.0 |
| 规格: | 200ul | 产品价格: | ¥2800.0 |
| 产品编号 | bs-10326R |
| 英文名称 | phospho-HDAC5 (Ser259) Rabbit pAb |
| 中文名称 | 磷酸化组蛋白去乙酰化酶5抗体 |
| 英文别名 | HDAC5(phospho S259); p-HDAC5(phospho S259); HDAC5(phospho-Ser259); HDAC5(phospho-S259); p-HDAC5(Ser259); p-HDAC5(S259); HD 5; HD5; HDAC 5; Histone deacetylase 5; KIAA0600; NY CO 9; Antigen NY CO 9; FLJ90614; HDAC5_HUMAN; Antigen NY-CO-9. |
| 产品应用 | WB=1:500-2000, IHC-P=1:100-500, IHC-F=1:100-500, IF=1:100-500 Not yet tested in other applications. |
| 交叉反应 | Human, Mouse, Rat (Chicken, Cow, Horse, Rabbit) |
| 抗体来源 | Rabbit |
| 免疫原 | KLH conjugated synthesised phosphopeptide derived from human HDAC5 around the phosphorylation site of Ser259 |
| 亚型 | IgG |
| 性状 | Liquid |
| 纯化方法 | affinity purified by Protein A |
| 克隆类型 | Polyclonal |
| 理论分子量 | 123 kDa |
| 浓度 | 1mg/ml |
| 储存液 | 0.01M TBS (pH7.4) with 1% BSA, 0.02% Proclin300 and 50% Glycerol. |
| 研究领域 | Cardiovascular > Heart > Hypertrophy Epigenetics and Nuclear Signaling > Chromatin Modifying Enzymes > Acetylation Epigenetics and Nuclear Signaling > Chromatin Modifying Enzymes > Acetylation > HDACs > Class II / Hda1 Class Stem Cells > Signaling Pathways > Wnt > HDACs |
| 亚基 | Interacts with AHRR. Interacts with BAHD1, BCOR, HDAC7, HDAC9, CTBP1, MEF2C, NCOR2, NRIP1, PHB2 and a 14-3-3 chaperone protein. Interacts with KDM5B. Interacts with MYOC. Interacts with GRK5. Interacts with DDIT3/CHOP. |
| 亚细胞定位 | Nucleus. Cytoplasm. Note=Shuttles between the nucleus and the cytoplasm. In muscle cells, it shuttles into the cytoplasm during myocyte differentiation. The export to cytoplasm depends on the interaction with a 14-3-3 chaperone protein and is due to its phosphorylation at Ser-259 and Ser-498 by AMPK, CaMK1 and SIK1. |
| 组织特异性 | Ubiquitous. |
| 翻译后修饰 | Phosphorylated by AMPK, CaMK1, SIK1 and PRKD1 at Ser-259 and Ser-498. The phosphorylation is required for the export to the cytoplasm and inhibition. Phosphorylated by the PKC kinases PKN1 and PKN2, impairing nuclear import. Phosphorylated by GRK5, leading to nuclear export of HDAC5 and allowing MEF2-mediated transcription.
Ubiquitinated. Polyubiquitination however does not lead to its degradation. |
| 相似性 | Belongs to the histone deacetylase family. HD type 2 subfamily. |
| 功能 | Responsible for the deacetylation of lysine residues on the N-terminal part of the core histones (H2A, H2B, H3 and H4). Histone deacetylation gives a tag for epigenetic repression and plays an important role in transcriptional regulation, cell cycle progression and developmental events. Histone deacetylases act via the formation of large multiprotein complexes. Involved in muscle maturation by repressing transcription of myocyte enhancer MEF2C. During muscle differentiation, it shuttles into the cytoplasm, allowing the expression of myocyte enhancer factors. |
| 保存条件 | Shipped at 4℃. Store at -20℃ for one year. Avoid repeated freeze/thaw cycles. |
| 注意事项 | This product as supplied is intended for research use only, not for use in human, therapeutic or diagnostic applications. |
| 背景资料 | Histones play a critical role in transcriptional regulation, cell cycle progression, and developmental events. Histone acetylation/deacetylation alters chromosome structure and affects transcription factor access to DNA. The protein encoded by this gene belongs to the class II histone deacetylase/acuc/apha family. It possesses histone deacetylase activity and represses transcription when tethered to a promoter. It coimmunoprecipitates only with HDAC3 family member and might form multicomplex proteins. It also interacts with myocyte enhancer factor-2 (MEF2) proteins, resulting in repression of MEF2-dependent genes. This gene is thought to be associated with colon cancer. Two transcript variants encoding different isoforms have been found for this gene. [provided by RefSeq, Jul 2008]. |
| 应用 | 推荐稀释比例 |
| {WB} | {1:500-2000} |
| {IHC-P} | {1:100-500} |
| {IHC-F} | {1:100-500} |
| {IF} | {1:100-500} |

Antigen retrieval: citrate buffer ( 0.01M, pH 6.0 ), Boiling bathing for 15min; Block endogenous peroxidase by 3% Hydrogen peroxide for 30min; Blocking buffer (normal goat serum,C-0005) at 37℃ for 20 min;
Incubation: Anti-Phospho-HDAC5 (Ser259) Polyclonal Antibody, Unconjugated(bs-10326R) 1:200, overnight at 4°C, followed by conjugation to the secondary antibody(SP-0023) and DAB(C-0010) staining

Hela(Human) Cell Lysate at 30 ug
293T(Human) Cell Lysate at 30 ug
Primary: Anti- Phospho-HDAC5 (Ser259) (bs-10326R) at 1/1000 dilution
Secondary: IRDye800CW Goat Anti-Rabbit IgG at 1/20000 dilution
Predicted band size: 119 kD
Observed band size: 119 kD
风险提示:丁香通仅作为第三方平台,为商家信息发布提供平台空间。用户咨询产品时请注意保护个人信息及财产安全,合理判断,谨慎选购商品,商家和用户对交易行为负责。对于医疗器械类产品,请先查证核实企业经营资质和医疗器械产品注册证情况。
文献和实验:使用 Anti-phospho-Akt (Ser473) Rabbit mAb 对石蜡包埋的人乳腺癌组织进行免疫组织化学分析。(图 A)使用免疫组化试剂盒M&R HRP/DAB Detection IHC Kit,抗体 1:100 稀释;(图 B) 采用普通免疫组化试剂盒,抗体 1:25 稀释。 图 6 免疫组化实验检测 Erk1/2 表达 注:使用 Anti-Erk1/2 Mouse mAb与p44/42 MAPK (Erk1/2)Rabbit mAb 对正常小鼠心脏组织进行免疫
at 10, 25, and 50 μM). At 24 h post-treatment, celllysates were obtained; SDS-PAGE and Western blotting were performed as described in Section 3, Methods. AR-A014418dose-dependent decreases of phospho-β-catenin (Ser33/37) and phospho-glycogen synthase
(Ser473)(193H12)Rabbit mAb,1:300,稀释,二抗是驴抗兔,1:2000,我是实验室的新手,刚呆俩月,受 此挫折,一头雾水,请过来人或者有经验的同学帮忙解答怎样解决,非常感谢! 碧峤 pAkt有两个位点,Ser473和Thr308,其中Ser473相对容易显色。如果显色失败,可能的原因:1 上样量过少,我们一般都是30μg;2 一抗孵育时间过短,我们一般24h~48h;3 一抗是否工作有待排除 米宝
技术资料暂无技术资料 索取技术资料





